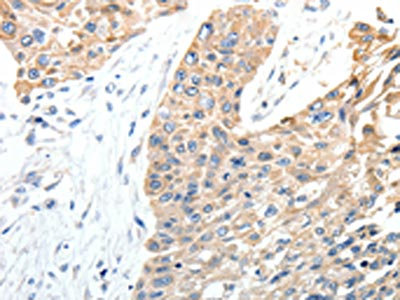

STEAP4 Antibody
-
中文名稱:STEAP4兔多克隆抗體
-
貨號:CSB-PA795802
-
規(guī)格:¥1100
-
圖片:
-
The image on the left is immunohistochemistry of paraffin-embedded Human cervical cancer tissue using CSB-PA795802(STEAP4 Antibody) at dilution 1/40, on the right is treated with synthetic peptide. (Original magnification: ×200)
-
The image on the left is immunohistochemistry of paraffin-embedded Human esophagus cancer tissue using CSB-PA795802(STEAP4 Antibody) at dilution 1/40, on the right is treated with synthetic peptide. (Original magnification: ×200)
-
-
其他:
產(chǎn)品詳情
-
Uniprot No.:
-
基因名:STEAP4
-
別名:STEAP4; STAMP2; TNFAIP9; Metalloreductase STEAP4; Six-transmembrane epithelial antigen of prostate 4; SixTransMembrane protein of prostate 2; Tumor necrosis factor, alpha-induced protein 9
-
宿主:Rabbit
-
反應種屬:Human,Mouse
-
免疫原:Synthetic peptide of Human STEAP4
-
免疫原種屬:Homo sapiens (Human)
-
標記方式:Non-conjugated
-
抗體亞型:IgG
-
純化方式:Antigen affinity purification
-
濃度:It differs from different batches. Please contact us to confirm it.
-
保存緩沖液:-20°C, pH7.4 PBS, 0.05% NaN3, 40% Glycerol
-
產(chǎn)品提供形式:Liquid
-
應用范圍:ELISA,IHC
-
推薦稀釋比:
Application Recommended Dilution ELISA 1:2000-1:5000 IHC 1:25-1:100 -
Protocols:
-
儲存條件:Upon receipt, store at -20°C or -80°C. Avoid repeated freeze.
-
貨期:Basically, we can dispatch the products out in 1-3 working days after receiving your orders. Delivery time maybe differs from different purchasing way or location, please kindly consult your local distributors for specific delivery time.
-
用途:For Research Use Only. Not for use in diagnostic or therapeutic procedures.
相關(guān)產(chǎn)品
靶點詳情
-
功能:Integral membrane protein that functions as NADPH-dependent ferric-chelate reductase, using NADPH from one side of the membrane to reduce a Fe(3+) chelate that is bound on the other side of the membrane. Mediates sequential transmembrane electron transfer from NADPH to FAD and onto heme, and finally to the Fe(3+) chelate. Can also reduce Cu(2+) to Cu(1+). Plays a role in systemic metabolic homeostasis, integrating inflammatory and metabolic responses. Associated with obesity and insulin-resistance. Involved in inflammatory arthritis, through the regulation of inflammatory cytokines. Inhibits anchorage-independent cell proliferation.
-
基因功能參考文獻:
- These findings suggest that increased STEAP4 mRNA expression is associated with inflammatory stimuli, whereas lower STEAP4 expression is associated with obesity in human islets. PMID: 28405880
- STEAP4 plays role in metal homeostasis is critical to the maintenance of cellular homeostasis , and in preventing the onset of metabolic disease. [review] PMID: 28576871
- a down regulation of STEAP4 and up-regulation of HIF-1alpha are observed in morbidly obese patients PMID: 27058639
- The expression of TNFAIP9 significantly decreased in the adipose tissue of obese children, and its levels are closely related to blood lipid level, insulin resistance, and obesity. PMID: 27706555
- the expression of STEAP4 was significantly downregulated in the adipose tissue of obese children. PMID: 27808366
- Some SNPs of the STEAP4 gene altered the risk of developing a metabolic syndrome in the Han Chinese population. PMID: 26510124
- These data suggest that STAMP2 is required for prostate cancer progression and thus may serve as a novel therapeutic target. PMID: 25680860
- may interact with mitochondria [review] PMID: 24643198
- Our results show increased mRNA expression of STEAP4 and NGAL in human visceral adipose tissue in obese patients. PMID: 23179203
- Our findings revealed that STAMP2 gene polymorphisms are likely to significantly contribute to the risk of MetS in male Han Chinese population. PMID: 23953178
- three polymorphisms (rs8122, rs1981529 and rs34741656) of STAMP2 gene may be not related with type 2 diabetes mellitus in Xinjiang Uygur population PMID: 23134829
- STEAP4 was highly induced in human adipose cells differentiated in the presence of 1,25D. PMID: 23553608
- STAMP2 antagonizes HBx-mediated hepatocyte dysfunction, thereby protecting hepatocytes from hepatitis B virus gene expression. PMID: 23095254
- STEAP4 genetic variations are likely to be associated with obesity-related insulin resistance in Uygur Chinese general population. PMID: 21718614
- STEAP4 is expressed on monocytes and neutrophils in peripheral blood of patients with rheumatoid arthritis. PMID: 22244520
- STEAP4 might potentially suppress the pathogenesis of TNFalpha-induced arthritis such as rheumatoid arthritis. PMID: 21633911
- an association of the common variation rs1981529 (Gly75Asp, 224A/G) in the STEAP4 gene with obesity in Uygur general population PMID: 21933608
- Decreased STAMP2 expression (mRNA and protein) might reflect visceral adipose dysfunction in subjects with obesity and type 2 diabetes. PMID: 21849520
- The knockdown of STEAP4 inhibits insulin-stimulated glucose transport and GLUT4 translocation via the attenuated phosphorylation of Akt, independent of the effects of EEA1. PMID: 21468601
- There was no association of the three polymorphisms (rs8122, rs1981529 and rs34741656) in the STAMP2 gene with essential hypertension in Xinjiang Uygur population. PMID: 21287513
- STEAP 4 genetic polymorphisms may be associated with metabolic syndrome risk in Chinese Uygur population. PMID: 21287516
- Fourteen novel and six known single nucleotide polymorphisms (SNPs) including 2 nonsynonymous SNPs in the STEAP4 gene were identified. SNPs rs8122 and rs1981529 were significantly associated with the metabolic syndrome phenotype in females. PMID: 21044749
- common polymorphisms of STAMP2 are unlikely to significantly contribute to the risk of the metabolic syndrome in the general population PMID: 20382686
- Results demonstrate that STEAP4 does not influence human adipocyte differentiation, but it participates in regulating the insulin sensitivity of human adipocytes. PMID: 20127040
- Human WAT STAMP2 associates with obesity and insulin resistance independently of adiponectin. PMID: 18381574
- Down-regulation of STEAP4 is associated with obesity in humans. PMID: 18430367
- TIARP/STAMP2 is highly upregulated in 3T3-L1 cells and hMSC-Ad by IL-1beta and might, therefore, modulate proinflammatory and insulin resistance-inducing effects of IL-1beta. PMID: 19289123
- STEAP4 associates with focal adhesion kinase (FAK) and regulate the activity of FAK through Y397 phosphorylation. PMID: 19787193
顯示更多
收起更多
-
亞細胞定位:Cell membrane; Multi-pass membrane protein. Golgi apparatus membrane; Multi-pass membrane protein. Early endosome membrane; Multi-pass membrane protein.
-
蛋白家族:STEAP family
-
組織特異性:Ubiquitous. Highly expressed in adipose tissue. Expressed in placenta, lung, heart and prostate. Detected at lower levels in liver, skeletal muscle, pancreas, testis and small intestine. Highly expressed in joints of patients with rheumatoid arthritis and
-
數(shù)據(jù)庫鏈接:
Most popular with customers
-
-
YWHAB Recombinant Monoclonal Antibody
Applications: ELISA, WB, IHC, IF, FC
Species Reactivity: Human, Mouse, Rat
-
Phospho-YAP1 (S127) Recombinant Monoclonal Antibody
Applications: ELISA, WB, IHC
Species Reactivity: Human
-
-
-
-
-